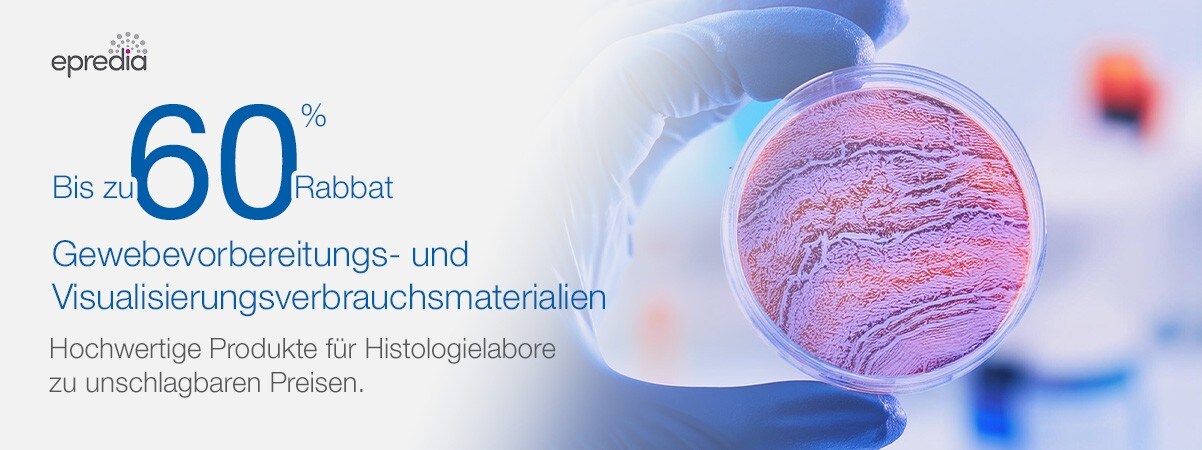
Epredia Epredia

Verbrauchsmaterialien für die Gewebevorbereitung und Visualisierung
Steigern Sie Ihre Effizienz in der Histologie mit bis zu 60 % Rabatt auf Verbrauchsmaterialien zur Gewebevorbereitung und -visualisierung
Entdecken Sie hochwertige, im Labor getestete Produkte zu unschlagbaren Preisen – nur für kurze Zeit.
Histologielabore sind auf Präzision und Zuverlässigkeit angewiesen, und wir sind hier, um Ihre wichtige Arbeit zu unterstützen. Genießen Sie für kurze Zeit bis zu 60 % Rabatt auf unser breites Sortiment an Verbrauchsmaterialien für die Gewebevorbereitung und -visualisierung. Egal, ob Sie mit modernster Bildgebung arbeiten oder Ihre Gewebeverarbeitungsabläufe optimieren, wir haben alles, was Sie benötigen.
Verwenden Sie den Promo-Code 21628, um bis zum 31. Oktober 2024* auf die Sonderpreise zuzugreifen.